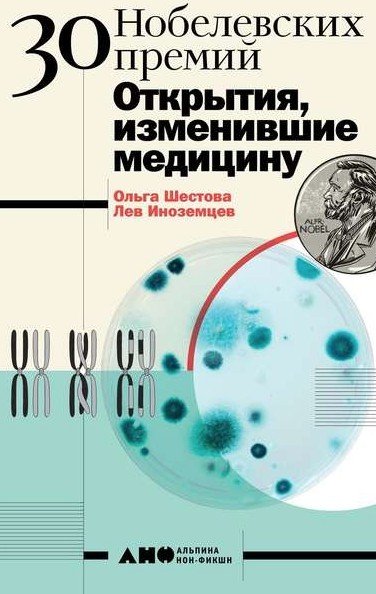

Описание
Книга посвящена разработке серверных приложений и клиент-серверных архитектур на Python. Рассказано о поддержке SSL в Python 3, представлены примеры работы с протоколами TCP, UDP, HTTP, SMTP, IMAP, FTP, RPC, взаимодействия с сервисами DNS. Освещена работа с электронной почтой в приложениях. Описаны цели протокола TLS и методы их достижения на Python. Подробно описаны возможности модуля asyncio, входящего в состав Python 3.4, даны рекомендации по разработке сетевых приложений с использованием веб-фреймворков Flask и Django.
Книга рассказывает о разработке на языке Python клиент-серверных проектов, взаимодействующих с сетью и веб-приложениями. Также всесторонне рассматривается поддержка SSL.
В книге описаны:
ключевые возможности SSL в Python 3,
цели протокола TLS и методы их достижения на Python,
архитектура серверов и создание серверных приложений,
работа с электронной почтой в приложениях,
применение Flask и Django для создания сетевых веб-приложений.
Для программистов
Формат: скан PDF
- 🎯 Лучшее качество материала. Оригинальные курсы отличного качества со скидкой до 99%
- 📩Моментальная обработка заказа. Доступ пpeдоcтавляeтcя нa oблaчном хранилищe.
- 📂Пoсле оплaты открывается доступ к ссылке на облачное хранилище откудa Вы можетe поcмoтреть onlinе или скaчaть.
- 👍 Гарантия получения результата. Все обучение добавленное на проекте выкуплено и полностью в наличии
-
Надежная оплата несколько вариантов на выбор: платите как вам удобно